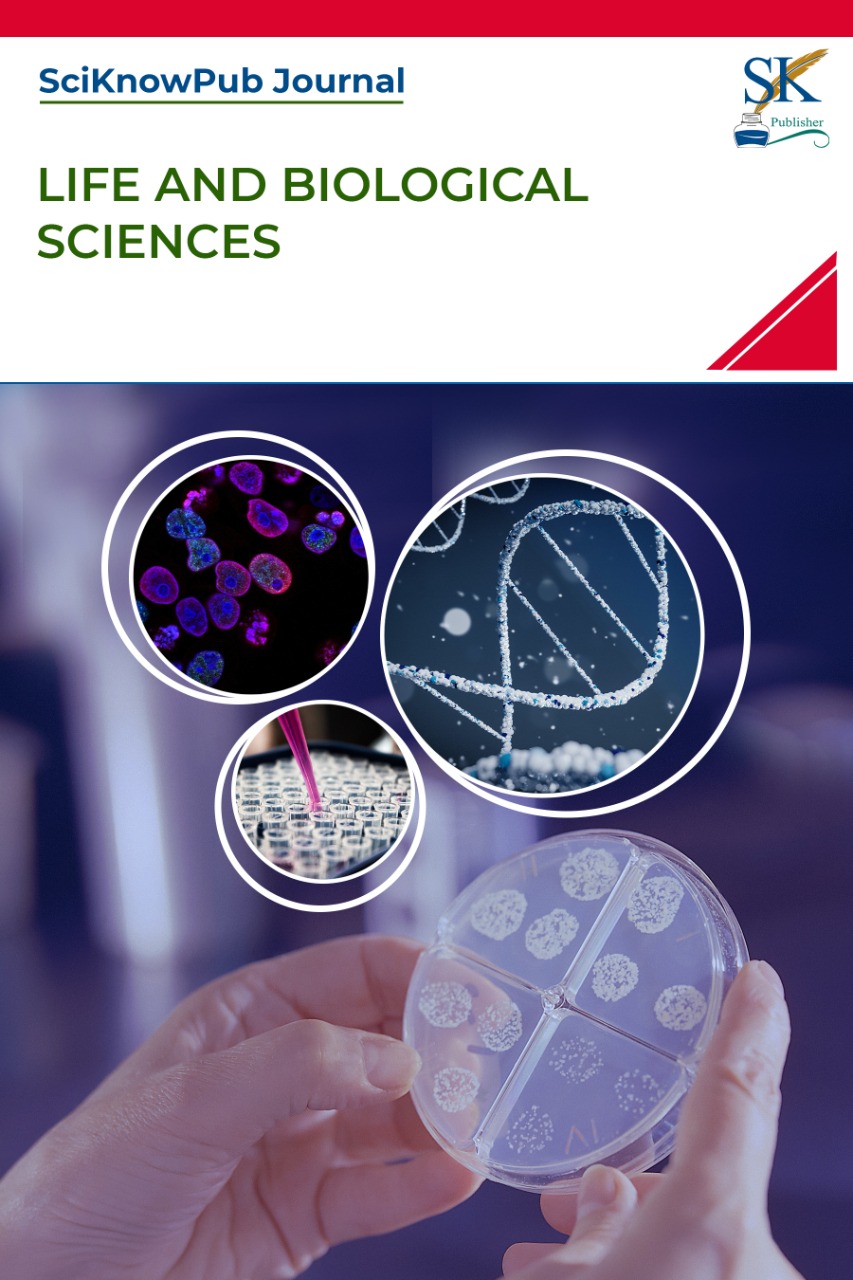

Life and Biological Sciences
Editor-in-Chief: Invited
Aims & Scope
SciKnowPub Journal of Life and Biological Sciences provides worldwide platform to publish advances and fundamental information relating to scientific study of life and biology related fields. The articles are published in the mode of original research, review and proceedings. Research fields covered include: bioinformatics, biotechnology, biochemistry, botany, food sciences, microbiology, zoology, physiology, physical education, sports science and related disciplines.
FEATURED JOURNAL ARTICLES

Ornare sed consequat
$ 95.00$ 81.00
There are many variations of passages of Lorem Ipsum available, but the majority have suffered alteration in some form, by injected humour, or randomised words which don't look even slightly believable.
Availability: In Stock


